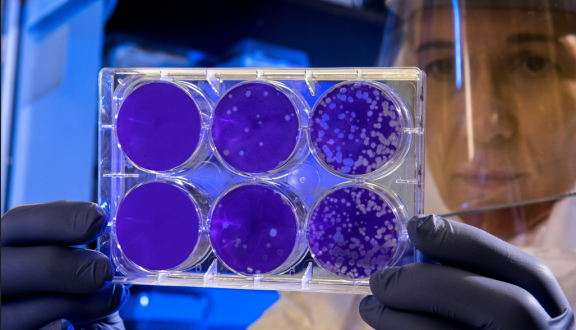
Una ricercatrice osserva in controluce alcune piastre di Petri in un laboratorio scientifico

Natalia Milazzo

Natalia Milazzo, giornalista, è specializzata in comunicazione tecnico-scientifica. Lavora da molti anni nell’ambito dell’informazione indipendente e basata sulle fonti scientifiche, in particolare nel campo della salute, dell’alimentazione, dell’ambiente e dei diritti del consumatore. Collaboratrice di Zadig e redattrice di Scienza in rete, ha collaborato con il ministero della Salute e con molti istituti ed enti di divulgazione e ricerca scientifica. Prima di tutto ciò si è laureata in Lettere classiche all’Università degli Studi di Milano.
di Natalia Milazzo, Silvio Garattini
16 Jan 2026
di Natalia Milazzo
7 Dec 2025
di Natalia Milazzo
18 Nov 2025
di Natalia Milazzo
17 Oct 2025
di Natalia Milazzo
26 Sep 2025
di Natalia Milazzo
5 May 2025
di Natalia Milazzo
20 Mar 2025
di Natalia Milazzo
13 Mar 2025
di Natalia Milazzo
8 Feb 2025
di Natalia Milazzo
6 Feb 2025
di Natalia Milazzo
20 Jan 2025
di Natalia Milazzo
13 Dec 2024
di Natalia Milazzo
18 Nov 2024
di Natalia Milazzo
17 Jun 2024
di Natalia Milazzo
15 Apr 2024
di Natalia Milazzo
18 Mar 2024
di Natalia Milazzo
3 Feb 2024
di Natalia Milazzo
19 Jan 2024
di Natalia Milazzo
18 Dec 2023
di Natalia Milazzo
13 Dec 2023
di Natalia Milazzo
1 Nov 2023
di Natalia Milazzo
4 Oct 2023
di Natalia Milazzo
17 Aug 2023
di Natalia Milazzo
14 May 2023
di Natalia Milazzo
15 Apr 2023
di Natalia Milazzo
20 Mar 2023
di Natalia Milazzo
8 Mar 2023